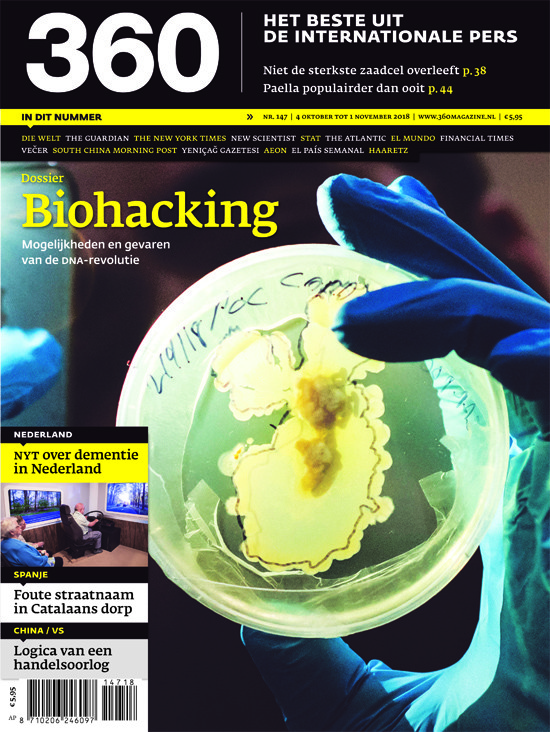

Misfits' Architecture | The Jewish Chronicle | The Wrap | Mental Floss | SAPO | Türkiye Today | The Palestine Chronicle | Amwaj.media | Equator | We Make Money, Not Art | Uitgeverij Pluim | Koaci | El Mostrador | Envoy | Guanchazhe Wang | Seneweb | Notes from Poland | Greek Reporter | Debunk Media | České noviny | Il Gazzettino | Gazeta Express | L’Express de Madagascar | n-tv | Radio Praag Internationaal | Bidoun | Berliner Morgenpost | Artforum | The Punch | Æther Mug | Respekt | The Insider | K. | Actualite.cd | NHK | The Sun | Colossal | Small Wars Journal | National Catholic Register | Amarillo Globe-News | Verstka | Diario Correo | Diário de Notícias | Channel News Asia | My Modern Met | European Western Balkans | Reactor | Actu Cameroun | ScienceDirect | Der Tages-Anzeiger | Persuasion | Jornada | L’Express | Verdens Gang | The Jakarta Post | The Kathmandu Post | Rappler | Afrik | Agência Pública | The Brussels Times | Handelsblatt | The Himalayan Times | Aftenposten | Jakarta Globe | The Minnesota Star Tribune | Gestión | VnExpress | San Antonio Express-News | Houston Chronicle | The New Arab | Diario de Mallorca | CBC News | Belfast Telegraph | Ekonomitsjna Pravda | Words Without Borders | Liverpool Echo | News.com.au | The Scotsman | Africa Radio | Vatican News | La Hora | Egypt Today | Quanta Magazine | Delfi | Okraj | Sapiens | Divergentes | Irozhlas.cz | Dernières Nouvelles d'Algérie | Rubryka | La Estrella de Panamá | KabulNow | Cinco Días | L'Observateur Paalga | La Patilla | Scena9 | n+1 | New York Post | Al Mayadeen | Georgia Today | Die Kleine Zeitung | ABC (Australian Broadcasting Corporation) | Tactical Media Files | El Nacional | The Times of India | Israel Hayom | Orion Magazine | Le Soir | Dhaka Tribune | Space.com | Iceland Monitor | Daily Post | Hoy | Sudan Tribune | The Rio Times | El Periódico de Canarias | The Seattle Times | Pulse | Nicaragua Investiga | Emerging Europe | Radio Okapi | La Prensa | Kyunghyang Shinmun | Excélsior | NDTV | Tirana Times | El Deber | Informer | The Standard | The Star | Science | Svenska Dagbladet | W Radio | Blick | Deccan Herald | Tunisie Numérique | Associated Press | The Hollywood Reporter | The Korea Herald | Alwihda Info | Milenio | The Citizen | Variety | Miami Herald | NK News | L’Orient-Le Jour | RFG Magazine | Suriname Herald | Kapital | France 24 | NPR | Panorama | El Comercio | The Kyiv Independent | Axios | Dawn | StarNieuws | Sky News | CGTN | Kapitalis | USA Today | El Ciudadano | ORF | Hindustan Times | Ars Technica | Aktuálně | Portal Novosti | New Lines Magazine | De Ware Tijd | Diario Libre | Tama Media | Radio-Canada | Al Arabiya English | European Correspondent | Swiss Info | TOLOnews | Penn Press | The Slovak Spectator | Substack | RaiNews | Fox News | Taiwan News | Mashable | Middle East Monitor | Barron’s | Etemaad | Kyodo News | The Korea Times | BioBioChile | CBS News | Wakat Séra | The News International | El Telégrafo | The Dial | The Mayor | The New Zealand Herald | Inside Climate News | CNBC | Africanews | The Japan Times | Le Parisien | Voice of America | Ta Nea | Vísir | The Tehran Times | Euronews | Greenpeace Magazin | Columbia Journalism Review | NBC | I Kathimerini | The Jerusalem Post | ABC News | Expressen | The Nation Thailand | La República | Parbode | Solomon | Americas Quarterly | Noema | Kosovo 2.0 | New Left Review | Minority Africa | Página 12 | The Drift | Etilaatroz | The Tablet | Correctiv | Muwatin | 444 | Revista 5W | IDHEAS | Zetland | Oekrajina Moloda | It's Nice That | Coda Story | Kyiv Post | Imagine 5 | The Baffler | Andreas Krieg | Deník N | Branded content | LeidenAsiaCentre | Sinembargo | Galore Interviews | Ambo|Anthos | Knowable Magazine | Narratively | The New Statesman | Meduza | Truthout | New Frame | Al-Hurra | Domani | Reasons to be Cheerful | Syria Untold | Ukrinform | Al-Quds Al-Arabi | Psyche | Chugan Kyunghyang | The Philosophical Salon | Heti Világgazdaság | Vita e Pensiero | Fordham University Press | Nadiaharhash.com | First Things | Internationaal Monetair Fonds | La Presse de Tunisie | NZZ am Sonntag | Afghan Women News | Gandhara | This Week in Palestine | Eurasianet | Dowody na Istnienie | The Expres Tribune | Apollo Magazine | Onet Wiadomosci | The Middle East Institute | Phi Kappa Phi Forum | Coffee or Die | OCCRP | Radio Free Europe / Radio Liberty | History Today | Vzgliad | Lenta.ru | Ara | Nieuw Amsterdam | The Huffington Post | El Español | Motherland Magazine | The Lancet | Boston Review | Pause | Boing Boing | Interview Magazine | Submarine | Intelligent Life | Hollands Diep | Época | Ogonjok | True Africa | Etiqueta Negra | El Tiempo | Buzzfeed | Jeune Afrique | Sisa Journal | The Paris Review | El País Colombia | Shaffaf | O Globo | Singapore Scene | Blog Wangyi | Irish Independent | Maclean's | Montreal Gazette | Koran Tempo | Business Insider | Toronto Star | Rand Daily Mail | Xin Zhoukan | Welt am Sonntag | The Culture Trip | Jacobin | Gizmodo | Libération | Blouin News | IRIN News | Mali Actu | The Millennium Project | The Register | The Globalist | Rolling Stone | Now | NewsNext | The Indian Express | Folha de São Paulo | Jornal de Notícias | Phys.org | Kommersant | The East African | Den | Le Républicain | Jingji Cankao Bao | Myanmar Now | Revue XXI | Delo | Politis | Contrepoints | Numerama | Le Nouvel Observateur | 20 minutes | L'Orient Littéraire | Southeast Asia Globe | Kommersant-Dengi | The New Khaleej | Shun Po | Der Standard | La Presse | The New Age | Al-Masry Al-Yoem | Al Modon | Romania Libera | Uitgeverij Xtra | Your Middle East | Fenghuang Wang | Recode | New Republic | Jahan-E Sanat | Amin | Fusion | Il Foglio | Dezeen | Télérama | Nanzao | Cityscapes | Standpoint | Granta | Al Safir | Ekspert | Lucky Peach | La Nacion | Foresight | Le Vif | Alternet.org | Chosun Ilbo | Svobodne forum | Jyllands-Posten | Changjiang Shangbao | Exame | Der Freitag | Efecto Cocuyo | 14ymedio | Al-Ittihad | Rossia v Globalnoj Politike | scroll.in | Tuoi Tre | Dinero en imagen | Hürriyet | Yediot Aharonot | NIN | Frankfurter Rundschau | Al-Jumhuriya | Leaders | The Verge | Al Monitor | Yeni Safak | Le Monde Magazine | The Clinic | Vreme | Vzglyad | Spiked | D (La Repubblicadelle Donne) | Vice Italia | Pressian | Univision | Ozguruz | Napi | Frankfurter Allgemeine Sonntagszeitung | Pacific Standard | Magyar Nemzet | BBC | Protagon | Mediapart | The Sunday Times Magazine | New Zealand Listener | Novaya Gazeta | Al-Arabi Al-Jadid | Il Post | Carnegie Middle East Center | Hankyoreh21 | Nihon Keizai Shimbun | Global Times | Insight Crime | Le Soleil | Globus | Club Z | Dziennik Gazeta Prawna | The Perennial Plate | Fraternité Matin | Sahelien.com | Proto Thema | Mosaic Science | Lebowksi | Quartz Africa | Tagesschau | San Francisco Chronicle | Moskovski Komsomolets | Russkiy Reporter | Al-Hayat | WIRED | Mashallah News | Artsy | El Watan | VPRO | Rudaw | Kurdistan24 | ESPN | Smithsonian Magazine | Le Monde Diplomatique | ABC | Ukrainska Pravda | Daily Nation | Outlook | All4syria | Jiemian | ZEITmagazin | Clarín | OkayAfrica | The Baltimore Sun | Salon | Reflex | GQ | The Ringer | Longreads | Algerie-Focus | Il Messaggero | iDNEZ.cz | Le Pays | TelQuel | Roads & Kingdoms | The Diplomat | Die Wochenzeitung | Dilema Veche | Médor | Duanchuanmei | India Today | OZY | Muftah | The Hill | Guoji Jinrong Bao | El Faro | ESPN The Magazine | Il Fatto Quotidiano | The Saturday Paper | Wirtschaftswoche | Outside | El-Watan Weekend | +972 Magazine | Proceso | Qiangzhan Wang | Visão | Nezavisimaya Gazeta | Magyar Idők | Marginalia | IQ | Le Desk | Expresso | Adevărul | Semana | Wprost | Khaosod English | The Telegraph | Le Figaro | Gastro Obscura | Thrillist.com | Syria TV | InoSMI | Los Angeles Review of Books | Topic | Bangkok Post | The Slovak Spectator | The Sydney Morning Herald | Bloomberg Businessweek | The Daily Maverick | El Estimulo | The California Sunday Magazine | Il Manifesto | Meem | The Village Voice | Politiken | El Nuevo Herald | Detroit Free Press | Khaosod | Chinadialogue | DailyO | Kafa | Arti Gerek | Sözcü | NewsDay | Caijing Wang | Le Devoir | abcúg | Himal Southasian | Asia by Africa | El Nuevo Diario | Brand Eins | Ensia | Tygodnik Powszechny | Deutsche Welle | Yeniçag | Veçer | The Daily Beast | World Politics Review | Sächsische Zeitung | Zhongguo Qingnian Bao | Slate | Business News | Duanchuanmei (The Initium) | RGP | 52 Insights | Shun Po Monthly | Il Dubbio | Diario de Sevilla | Asahi Shimbun | El Independiente | Frontier | The Conversation | Asia Times | Diken | Gazete Duvar | Epic | Arab News | Forbes | El País Semanal | Sixth Tone | Radii | Africa is A Country | Dagens Nyheter | Die Presse | The Observer | The Malay Mail Online | Vecernji List | Istinomer | Nexos | Cicero | Hospodarske Noviny | Gazeta.ru | New York Magazine | The Times Literary Supplement | The Walrus | Takie Dela | Stern | The Conversation Africa | The New Federalist | Falter | P24 Turkey | Cubanet | Harpers | Berliner Zeitung | Undark | Kurier | Polygon | EJ Insight | Ming Pao | www.chappatte.com | Novosti | Il Venerd di Repubblica | STAT | Esquire | UnHerd | Quillette | Aera | OjoPúblico | Daily News & Analysis | Criterio | El Universal | La Tercera | La Stampa | Reaction | Vanity Fair | Time Magazine | The Irish Times | Batenka | Are We Europe | Bento | Okaz | Radio Free Asia | Gatopardo | Stuff | Novi Magazin | Le360 | SingularityHub | The Reporter | La Vanguardia | Dongfang Ribao | Apple Daily | Raseef22 | The Caravan | Vice | Mada Masr | El Universo | Chilevisión Noticias | onEarth | Radio Farda | LinkedIn | Kompas | Infobae | HLO | Bloomberg | Vedomosti | Nautilus | Computer Bild | The Big Issue | The Next Web | Caixin Zhoukan | Confidencial | The New York Times Magazine | Sabah | Népszava | Live Mint | The New York Times Style Magazine | The National Interest | La Repubblica | Xinhua Wang | Rede Brasil Atual | Letras Libres | Prospect | Polityka | Tempo | El Espectador | The Times of Israel | National Review | CNN | The Christian Science Monitor | Middle East Eye | The Los Angeles Times | 1843 Magazine | El Diario | Literary Hub | Vulture | The National | Baodaozhe (The Reporter) | La Libre Belgique | Politico | The Globe and Mail | Válasz Online | New Statesman | Die Welt | Jutarnji List | The Daily Telegraph | Grist | Die Tageszeitung | South China Morning Post | The Nation | The Wire | Foreign Policy | The Sunday Times | NRK | Kaiser Health News | Inc. | Profil | Daraj | Myanmar Times | L'Espresso | The Moscow Times | London Review of Books | IranWire | The Point | Daily Mail | Undici | De Balie | Mainichi Shimbun | Mail & Guardian | The Continent | International Crisis Group | Animal Político | CIVICUS | The Times | The Hindu | Knopf Doubleday Publishing Group | Expert | Revista Late | Project Syndicate | Al Jazeera | AAWW | Guernica | The Boston Globe | Perspective Daily | Internazionale | El Mundo | The New York Review of Books | Environment & Energy Publishing | Yale Environment 360 | The Independent | Haaretz | Die Zeit | Popular Mechanics | The News on Sunday | Free Will Astrology | Reuters | Der Tagesspiegel | BirGün | Forge | Le Temps | Rest of World | Bellingcat | Fortune | Weixin (WeChat) | The Wall Street Journal | Mekong Review | Newsweek | P.M. Magazin | Il Sole 24 Ore | Corriera della Sera | De Bezige Bij | African Arguments | FOCUS | Ethiopia Insight | Vsquare | The Economist | Courrier International | Quartz | Motherboard | The Art Newspaper | The Atavist Magazine | Christian Science Monitor | The Intercept | Places Journal | El País | Aeon | Vox | Nature | Frankfurter Allgemeine Zeitung | New Scientist | Global Voices | True Story Award | UNDP | L’Orient-Le Jour | Jornal de Negócios | Le Monde | Capital | Press Corner EU | The Observer Magazine | Gazeta Wyborcza | Revista Anfibia | The Elephant | Nikkei Asia | Público | El Confidencial | The Spectator | 360 Magazine | MIT Technology Review | The Straits Times | InStyle | de lage landen | Law & Liberty | Foreign Affairs | The Guardian (Nigeria) | GEO | The New Yorker | Süddeutsche Zeitung Magazin | The New York Times | Süddeutsche Zeitung | Neue Zürcher Zeitung | The Atlantic | Reportagen | Financial Times | The Guardian | Hakai Magazine | The Washington Post | Mother Jones | Der Spiegel | The Daily Business | The Critic